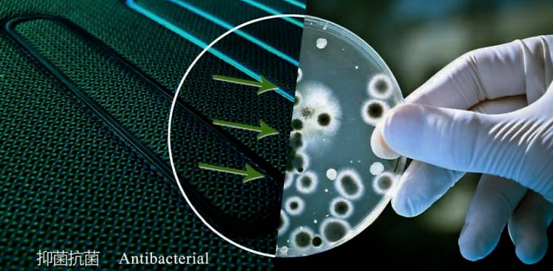

个人信息不会泄露给第三方
提到MAX或者PLUS,在手机领域一般是尺寸的加大,实际上与老款相比并没有质的提升。而今天聊的这台荣威RX5 MAX可不仅仅是车身加大,新车无论是从外观、动力、内饰配置上都有着MAX级别的改变,更是搭载了“智能座舱”以及“健康舱”。

荣威RX5 MAX直观来看确实比RX5大了一圈,采用了方方正正的设计风格,车身的线条也更加硬朗,比以往荣威SUV硬派了不少,这正是国人目前更加偏爱的设计。

这种设计风格其实与荣威的品牌命名有着相同之处,“荣”,有荣誉、殊荣之意,“威”,含威望、威仪及尊贵地位之意。板正的车身从视觉效果上传递出来一种踏实,稳重,很有威严的效果。

前脸最明显的改变就是采用了更大尺寸的悬浮鲸翼格栅,大面积的镀铬饰条装饰与大灯相互融合,一体感更强。其中熏黑的部分使得中网更具层次感,仿佛一块盾牌顶在车头,非常霸气。保险杠下方的银色防擦护板,暗示了荣威RX5 MAX有着不错的通过能力。

并且前大灯内部均采用LED光源,夜晚点亮之后铺路的效果非常不错。

车身侧面很明显的看出比RX5尺寸更大,RX5 MAX长宽高为4647mm、1891mm、1725mm,轴距为2760mm,相比RX5长91mm、宽36mm、高6mm,轴距增加了60mm,也能进一步加大车内的乘坐空间,带来更好地舒适性体验。

我们这台400TGI 自动四驱智能座舱至尊版采用了19寸风云轮毂,样式新颖,搭配了四条米其林PS4轮胎,一条胎的单价在1000元以上,很有诚意,并且能够为这台2.0T的发动机提供很好的抓地力。


尾部设计同样传递出一种很稳重的感觉,星海闪烁LED尾灯通过镀铬饰条相连接,与时下流行的贯穿式尾灯有所区分。下方的银色防擦护板与前方首尾呼应,搭配两边粗壮的排气出口,更具动感。

值得一提的还有RX5 MAX的后备箱容积,后排座椅完全放倒之后可以放置一个行车床,纵深很大。

聊完外观我们就发现RX5 MAX已经有着很大的改变了,但其实荣威RX5 MAX的内饰配置更是有着全方位的升级。首先,荣威RX5 MAX的内饰使用了全新的设计语言,采用中式风格的设计理念。

内饰最抢眼的就是这块14.3英寸2.5D曲面玻璃大屏,其中整合了大量强大的功能,内置了互联网汽车智能系统3.0-Pro,作为唯一基于全新高德星云AI引擎深度定制的车载导航,相较于传统的车机导航基本被用户抛弃的状态,互联网汽车智能系统3.0-Pro拥有与手机导航同步的准确性,可以不用边开车,边看手机导航,能够有效提升开车的安全性,不再手忙脚乱。在下方还有常用的物理按键,周围有着镀铬饰条的包裹,增加了内饰的豪华感。

档把采用了良好的人体工程学设计,官方设计表示有着47.8°最佳握感的角度,实际使用时感觉很贴合手型,搭在挡把上面很舒服,在周围则分布着调整车辆功能的物理按键。

荣威RX5 MAX还配有手机无线充电功能,不过RX5 MAX采用了立式充电的方法,在放下和拿起手机的时候更为顺手,并且更加节省车内的储物空间,非常具有创新感。


此外,12.3英寸全景AR模式虚拟仪表也是同样的硬核,搭配上AR-Driving实景驾驶辅助系统2.0,在中控屏幕上设定好导航位置后,可以在仪表盘上显示实景导航,在实际开车中遇到一些连续路口时,听导航容易走错,这次直接在实景屏幕上标出方向,能够减少走错路的情况,这一点真是无数新手司机的福音。

下方则是全新设计的多功能运动方向盘,方向盘的大小以及握感都非常舒服,皮质包裹很贴手。在后方还有换挡拨片的加持,对于一台SUV来说,换挡拨片实际使用的频率不会太高,但是可以很好地提升车内的运动感。


RX5 MAX还格外注重沉浸式体验,比如车内256色氛围灯,以及BOSE音响都能为车内成员带来更好地乘坐感受,氛围灯在晚上点亮之后非常唯美,BOSE音响在低音发挥也是一如既往的出众。

座椅采用了Nappa真皮,前排均配有电动调节,以及座椅加热功能,主驾驶座位还支持座椅记忆。实际坐起来的感受非常舒服,不过两侧的支撑感觉有一些多余,因为只有在以一定速度拐弯时才会感受到两侧给到的支撑力,日常使用时如果是一个偏瘦的驾驶员可能不会感受到两侧护腰的支撑。

后排空间不加大就已经足够了,加大60mm轴距之后的后排更为宽敞。中央扶手箱格外宽大,能够横向放置两个水杯,后排座椅坐起来和前排一样舒服,座椅的角度贴合后背,腿部支撑也很到位。

荣威的车机系统一直都标有着智能化和互联化科技标签,比如AR实景导航、Face ID等等。而RX5 MAX作为一款智能SUV,更是搭载了荣威的智能座舱。

坐上驾驶座位之后,首先激活SKYEYE天眼系统,系统通过摄像头进行面部识别,登录车主账号,按照记忆调整为车主模式,调整好座椅姿势、外后视镜角度、氛围灯、地图导航,等等一系列按照个人喜好的设置,均不需要动手完成。现如今大多数都是一家一台车,然而每次家里人开完车之后都要调整一系列设置,非常繁琐,天眼系统就很好的解决了这个问题。

此外,还有360°环境感知系统,车身四周配备3个毫米波雷达+6个全高清摄像头+12个超声波雷达,在日常倒车时候能够全方位的观察到车身周围的所有情况,并且还可以选择显示的方位,在实际使用中我发现摄像头的清晰度以及反映速度都非常不错,并且广角摄像头可以很好地帮助驾驶员看到盲区里的情况。

荣威RX5 MAX还配有AI-Pilot智能驾驶辅助系统,包括了ACC全速段自适应巡航,主动车道保持,车道偏离纠正,自动紧急制动,前方碰撞预警,和一系列能够有效提升驾驶安全性和便利性的系统,还可以完成自动泊车。

今年我们正在经历一个非常严峻的疫情,这导致国人越来越看重健康和环境问题,用车时的安全问题也同样上升了一个高度。这台荣威RX5 MAX可不止你想的那么简单,它是首批配备了荣威主动健康座舱的车型,能够通过主动隔断杀毒、主动舱内净化、主动面料灭菌实现三层净化保护。首先就是长期以来一直存在的PM2.5问题,PM2.5是指大气中空气动力学当量直径小于或等于2.5微米的颗粒物,也称为可入肺颗粒物。PM2.5粒径小,富含大量的有毒、有害物质且在大气中的停留时间长、输送距离远,因而对人体健康和大气环境质量的影响更大。

主动隔断杀毒是荣威RX5 MAX的第一道防护线,RX5 MAX配备了高效PM2.5滤芯,这套滤芯内部由两种不同过滤层组成,能够过滤0.2-0.3微米的颗粒物,也就是对于PM2.5以上的颗粒物有着高效的过滤作用,根据实验表明对于0.3微米的颗粒物过滤效果在95%。据3M提供的数据,冠状病毒直径为0.125微米,也就是说单凭滤芯的过滤不可能阻隔病毒。然而病毒通常要附着在其它载体才能传播,比如空气中的灰尘、液体喷雾、飞沫,但是当新型冠状病毒附着在载体上直径就变大了,新冠病毒通常会吸附在大于0.74微米的飞沫上,也就是滤芯可以过滤这些附着物上的病毒。

空调滤芯就相当于是我们的口罩,如果想要实现更好的车内净化效果,目前最普遍采用的做法是更换空调滤芯,荣威RX5 MAX则全部配有高效PM2.5滤芯,其过滤材料为纺粘工艺的预过滤层和熔喷工艺的超细纤维层,再经过静电驻极工艺,实验条件下对 0.3~5um颗粒的过滤效率可达95%以上。

第一道防护线不仅配备了高效PM2.5滤芯,还引入了UVC深紫外线消毒技术,能够提升车内消毒杀菌能力,首次应用在荣威RX5 MAX车型上。这套系统的原理就是利用紫外线光进行90秒照射空调滤芯(因为病毒和致病菌的体积比PM2.5大,通过空气循环基本上病毒都附着在空调滤芯表面),在90秒内能够杀菌95%,利用紫外线照射的方式将这里的病毒灭活,从而起到杀菌消毒的作用,从而为车内提供良好的空气环境。如此看来,如果我们在车内不打开窗户,只使用空调进行车内空气循环,车内的空气质量将保持一个极为安全的状态,病毒很难侵入到车内。

第二道防护线是主动舱内净化,从2013年开始,上汽集团就开始研发独立的空气过滤设备。在现有的荣威车型中,已经有不少车型的部分配置版本配备了独立的空气净化装置,就比如RX5 MAX车型。

荣威RX5 MAX车载空气净化器主要利用滤芯过滤颗粒物,荣威RX5 MAX全系配备“N95级”高效车载空气过滤器,根据实验表明,在一小时内对于直径在0.3-5微米的颗粒物过滤效果在95%左右。此外,集成在空气净化器中的负离子发生器发射出来的负离子与细菌结合后,使细菌产生结构的改变或能量的转移,导致细菌死亡,最终降沉于地面,同时负离子可与空气中的尘埃结合沉淀,负离子单独作用时,1h杀菌灭活率达到80%以上,配合净化过滤器杀菌灭活率达到99.5% 。
内饰是我们日常行车中接触最多的地方,日常开车说话、打喷嚏、飞沫都会附着在内饰面料表面,而我们平常又不会消毒车内,这使得内饰面料上很容易滋生细菌,所以车内采用抗菌面料也很重要,而第三层防护线就是主动面料灭菌,荣威RX5 MAX采用了纳米抑菌面料,高效抑菌,减少异味,控制抑菌率高达99%以上。


上汽集团切合当下环境推出的荣威健康仓,能够为用户在选择新车型时提供更多的选择。此外,不仅在保证空气质量安全上有着质的提升,荣威RX5 MAX全系标配了6安全气囊,并且采用了超高强度钢结构笼式车身,在行车安全上同样做足了保障。

这次试驾的是2.0T车型,最大马力231马力,最大扭矩370牛·米,对于这么一台紧凑级SUV来说这台发动机的动力储配已经足够了,加速表现非常优秀,并且在中后段之后也有着不错的动力表现,相较于一些小排量涡轮增压SUV车型在高速上表现动力疲软的现象,荣威RX5 MAX 2.0T车型则更具有优势,并且还有着四驱系统的帮助,在通过能力上能够很直观的区别于那些城市前驱SUV。

这台试驾车配备了6速双离合变速箱,在1档和2档之间的衔接还是刻意去感受还是会有所察觉,不过当速度上来之后,双离合变速箱换挡平顺丝滑的优势得以体现出来。

荣威RX5 MAX底盘调校还是偏向家用定位,对于路面上的震动过滤的十分彻底,你唯一可以感受到的就是由于悬架行程比较长,遇到大坑的时候会感觉像坐船一样忽悠,而高速过弯的时候也会出现一定程度的侧倾,不过这完全取决于它更偏向家用的定位有关。

荣威RX5 MAX相较于RX5无论是从外观还是内饰配置和动力表现上都有着强大的提升,此外还有着健康仓的加持,相信新款荣威RX5 MAX更加会深得顾家稳重的用户喜欢。此外,现在购车即享四重硬核豪礼,硬核现金礼12000元限时现金优惠。硬核金融礼超长24期0利率,1成首付,60期自由贷。硬核焕新礼,至高可享6000元增换购补贴。硬核流量礼,全系终身免费基础流量畅享智能网联生活。
本文转自:车扯